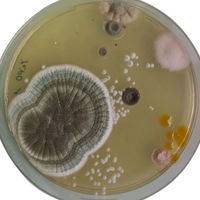
Atrumovis

07/26/2025

Atrumovis
1 Review
Atrumovis
2
Beachside Port'o'potty
Beachside port'o'potty that's weirdly nostalgic and childishly nauseating. Maybe taking a poop at a water park. Or your cool subaquatic babysitter who smokes. Smokey smoke smoke. Deep but pelagically sharp like Bint El Sudán worn on a funeral pyre.
So, I guess accurate to what a siren would actually smell like - pretty gross.
So, I guess accurate to what a siren would actually smell like - pretty gross.



Campfire
Salty notes
Jasmine
Kelp
Ambergris
Driftwood


Dorabella

































